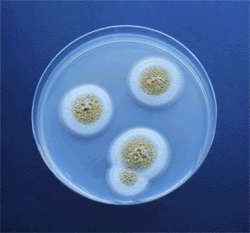

In Album: Trixter's Timeline Photos
Dimension:
1200 x 900
File Size:
133.04 Kb
1 person likes this.

, DrakonOmniVore reacted this

DrakonOmniVore



Trixter

DrakonOmniVore
BACTERIA GROWN FROM VEGGIE MEAT


DrakonOmniVore

DrakonOmniVore





